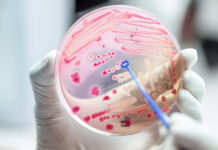
Gestione dell’asepsi cutanea nuova normativa sui biocidi

Ipsen è focalizzata sullo sviluppo di terapie innovative in oncologia, neuroscienze e malattie colestatiche epatiche rare per patologie molto sfidanti, per le quali l’offerta di trattamenti è limitata o assente.
Attenta al green e alla parità di genere, investe circa il 20% del fatturato in R&D, con una pipeline che si articola in un solido piano di sviluppo.
Con la general manager Patrizia Olivari parliamo di investimenti e aree di maggior fermento, mentre di pipeline parliamo con Chiara Marchesi, Medical & Regulatory Affairs director.
Ipsen è un’azienda biofarmaceutica presente in Italia dal 1990 e attiva in tre ambiti particolarmente sfidanti: quello oncologico, con particolare riguardo a tumore della prostata, della mammella, del rene, della tiroide e dei tumori neuroendocrini; quello neurologico, con la tossina botulinica a uso terapeutico, per la spasticità post ictus e la distonia cervicale; nelle malattie rare, con una focalizzazione specifica su quelle colestatiche.
«Sono aree d’intervento in cui Ipsen primeggia e in cui le alternative terapeutiche a disposizione dei pazienti sono alquanto limitate. In alcuni casi esiste un’unica terapia disponibile e in altri sono del tutto assenti», spiega Patrizia Olivari.

Terapie innovative: accompagnare il paziente nel percorso
«Come azienda siamo estremamente focalizzati sullo sviluppo di terapie innovative per cui stiamo lavorando anche per accelerare il processo di sviluppo dei farmaci, grazie alle costanti collaborazioni con centri di eccellenza di riconosciuta competenza».
Proprio per questo l’Italia rappresenta per Ipsen uno dei Paesi più importanti dal punto di vista della ricerca scientifica.
«Dall’altro lato siamo focalizzati anche sull’accelerare le possibilità di accesso al farmaco ai pazienti, che rimane il nostro fine ultimo. Sotto questo punto di vista stiamo allargando la nostra visione, offrendo anche servizi con un’ottica che non è solo di trattamento ma di presa in carico e accompagnamento del paziente nell’intero percorso di cura».
Green ed equità di genere
Come azienda farmaceutica attenta alle persone, Ipsen è impegnata a garantire un elevato livello di benessere dei propri dipendenti, sia in ottica di prevenzione, per esempio offrendo a tutti un check-up annuale gratuito, sia di parità di genere, avendo ottenuto la certificazione UNI/PdR 125:2022; un elemento questo che testimonia quanto inclusione e gender equality siano parte del suo DNA.
«Come ultimo aspetto, vorrei sottolineare il nostro impegno per la società, un impegno che si trasmette anzitutto con l’attenzione all’ambiente. In tal senso», prosegue Olivari, «abbiamo fatto delle scelte significative: abbiamo deciso di cambiare sede, trasferendoci a marzo 2025 in una struttura ecosostenibile con certificazione Platinum e, dallo scorso anno, abbiamo rinnovato il parco auto con mezzi esclusivamente full electric».
Team solido e gioco di squadra per fare la differenza
«Possiamo contare su un’organizzazione aziendale fatta di persone appassionate, competenti e unite, anche quando si tratta di lavorare in modo cross-funzionale; persone di cui ci prendiamo cura offrendo loro diversi servizi interni, dal supporto economico per l’asilo a quello per i libri scolastici, al fine di contribuire a un corretto equilibrio vita lavorativa-vita privata. Dall’altro lato, prestiamo un’attenzione estrema ai nostri interlocutori esterni.
L’obiettivo è fare la differenza offrendo non solo l’innovazione terapeutica ma una semplificazione in tutto il percorso. Del resto, ha enfatizzato Olivari, «il nostro leitmotiv è: testa, cuore, mani.
Con la testa pensiamo in grande, con il cuore, oltre che con coraggio e passione, cerchiamo di offrire soluzioni concrete; infine, le mani e il lavoro di squadra sono necessari perché solo grazie alla competenza trasversale presente in azienda potremo raggiungere efficacemente gli obiettivi di salute che ci siamo dati».
Puntare all’innovazione: obiettivi principali
La pipeline aziendale si è arricchita in modo importante negli ultimi anni con notevole avanzamento nello sviluppo o co-sviluppo di nuove molecole e soluzioni terapeutiche.
«C’è un filo conduttore che guida la visione di Ipsen nelle tre diverse aree: arrivare a fornire opzioni terapeutiche innovative che possano bloccare o rallentare il decorso di malattia in contesti clinici caratterizzati da alta complessità in cui le opzioni terapeutiche risultano limitate o assenti», spiega Marchesi.

Questo avviene attraverso una strategia basata sulla medicina trasformativa, che nei tre ambiti guarda all’innovazione in tutte le sue fasi: dalla ricerca preclinica alla clinica, attraverso tutte le fasi di sviluppo, all’accesso al mercato con una expertise nell’ambito della produzione e della distribuzione, fino alla raccolta dei dati real life, tanto più determinanti quanto più ci si muove nel mondo delle malattie rare, caratterizzate da numeri molto bassi ma con un’urgenza di accesso a innovazioni terapeutiche realmente trasformative.
«L’investimento in R&D è pari al 20% del nostro fatturato, con 700 colleghi impegnati in 3 siti di eccellenza: Parigi, Londra e Boston».
Una pipeline ricca e in crescita: l’ambito raro
«La nostra pipeline è in crescita in tutte le aree terapeutiche: nell’ambito raro negli ultimi anni si è registrato un importante impegno sul versante delle malattie colestatiche rare del fegato, un gruppo eterogeneo di patologie epatiche caratterizzate da un’alterazione del flusso biliare, di origine autoimmune o genetica, per cui l’azienda è diventata realtà di riferimento.
Oltre ai due farmaci già disponibili e rimborsati in Italia per il trattamento della colangite biliare primitiva (PBC) e della colestasi intraepatica familare progressiva (PFIC), abbiamo in corso studi clinici di fase II e III per il trattamento di due patologie a oggi sprovviste di opzioni farmacologiche disponibili: la colangite sclerosante primitiva (PSC) e l’atresia biliare (BA).
Un’altra area in cui è in corso uno studio di fase IIb è la fibrodisplasia ossificante progressiva (FOP), una patologia ultrarara dovuta a una mutazione genetica che porta alla formazione di tessuto osseo in sedi anomale, come muscoli, tendini e legamenti e caratterizzata da progressiva disabilità e riduzione dell’aspettativa di vita.
In questo momento, in UE non ci sono terapie che possano agire su questa patologia; la nostra molecola in studio, fidrisertib, blocca selettivamente il recettore mutato, riducendo la formazione di nuovo osso.
L’area oncologica
«In ambito oncologico, si assiste all’estensione dell’indicazione di cabozantinib per il trattamento dei tumori neuroendocrini – NET indipendentemente dalla sede primaria del tumore. Nell’ambito della neuro-oncologia è in studio tovorafenib per il trattamento dei gliomi a basso grado dell’età pediatrica con alterazioni del gene BRAF.
In oncoematologia è in sviluppo un trattamento orale non chemioterapico, tazemetostat, in combinazione con altre molecole per il linfoma follicolare di seconda linea. Si tratta di un trattamento epigenetico, first in class, che mira a modificare l’espressione dei geni senza alterare la sequenza del DNA. Tazemetostat nello specifico inibisce una metiltransferasi degli istoni (EZH2), la cui disregolazione può portare a sviluppare un linfoma follicolare.
Novità nelle neuroscienze
Sul versante delle neuroscienze, ambito in cui Ipsen è presente in Italia da oltre 30 anni, il focus è rappresentato dalla tossina botulinica: «da un lato, la tossina botulinica di tipo A per la quale sono in corso due studi fase III per l’emicrania cronica ed episodica; dall’altro un esteso programma di fase II focalizzato su una nuova generazione di neurotossine ricombinanti progettate per prolungarne l’effetto terapeutico (LANT).
Queste tossine long acting sono in studio per una serie di indicazioni differenti: a scopo terapeutico, l’attenzione va sulla spasticità degli arti superiori post ictus, la distonia cervicale e l’emicrania; per quanto concerne la parte estetica, il focus è dato dalle rughe glabellari. Si tratta dunque di un programma ricco di innovazioni e nuovi meccanismi d’azione che punta come sempre a fornire risposte in ambiti complessi in cui le opzioni terapeutiche risultano estremamente limitate», conclude Marchesi.
Articolo realizzato in collaborazione con Ipsen